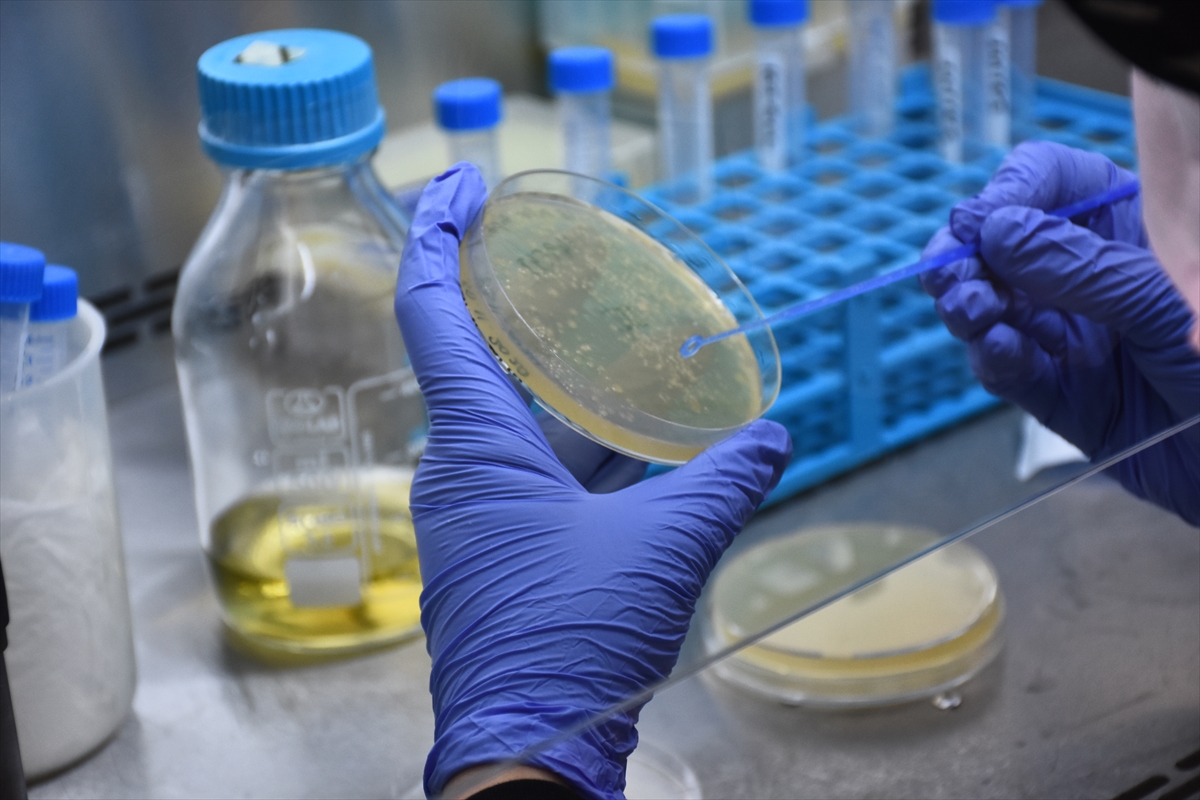
20210111-2-46292116-61436783-web.jpg

Türkiye'nin ilk mRNA aşısının geliştirildiği Selçuk Üniversitesi'nden flaş açıklama! Ne zaman kullanılabilecek?
Selçuk Üniversitesi'nde (SÜ), yeni tip koronavirüse (Kovid-19) karşı geliştirilen Türkiye'nin mRNA teknolojisine dayalı ilk aşısının, yaz aylarında insanlığın hizmetine sunulması hedefleniyor.
Türkiye'de Ege Üniversitesi, Selçuk Üniversitesi, Erciyes Üniversitesi, Mehmet Ali Aydınlar Üniversitesi, Acıbadem Labmed Sağlık Hizmetleri AŞ, Ankara Üniversitesi, İzmir Biyotıp ve Genom Merkezi, Boğaziçi Üniversitesi, Bezmialem Vakıf Üniversitesi, Ortadoğu Teknik Üniversitesi ve Koçak Farma, Kovid-19 aşısı için çalışma yürütüyor.

Selçuk Üniversitesi (SÜ) Tıp Fakültesi Tıbbi Genetik Anabilim Dalı'nda ise TÜBİTAK desteğiyle Türkiye'nin mRNA aşısı için çalışma yapılıyor.

Aşı geliştirme projesinin yürütücüsü Selçuk Üniversitesi Tıp Fakültesi Tıbbi Genetik Anabilim Dalı Öğretim Üyesi Doç. Dr. Nadir Koçak yaptığı açıklamada, mRNA teknolojisinin 3. jenerasyon aşı teknolojisi olarak dünyada da yeni bir teknoloji olduğunu söyledi.

Selçuk Üniversitesi Tıp Fakültesi Tıbbi Genetik Anabilim Dalı olarak kanser aşıları üzerinde çalıştıklarını ifade eden Koçak, Kovid-19 salgınıyla mücadele alanında aşı geliştirme çalışmalarına başladıklarını anlattı.
Koçak, geçen yılın haziran ayının ortasında başladıkları aşı çalışmalarının devam ettiğini vurgulayarak, şunları kaydetti:
"mRNA teknolojisiyle çalışan grupların aşı sürecini önde tamamlayacaklarını tahmin ediyorduk. Biz de hazırlıklarımızı buna göre yaptık ve özellikle bu grupları takip etmeye çalıştık. En büyük amaçlarımızdan biri bu teknolojiyi ülkemize kazandırmaktı. Başladıktan kısa bir süre sonra eksikliklerimizi tamamladık, protokollerimizi optimize ettik. Kendi dizaynlarımızı oluşturmaya başladık. BioNTech ve Moderna'dan yaklaşık 8 ay sonra çalışmaya başladık. Bu bir dezavantaj gibi görünse de geç başlamak bize şu olanağı verdi, dünyada virüs proteinin stabilitesi ile ilgili son yayınları da takip edebildik. Önde giden kuruluşların ne gibi dizaynlar yaptıklarını gördük. Daha stabil, daha etkin aşı geliştirme yönünde ilerledik."

Koçak, etkili sonuçlar alınabilecek bir molekül geliştirmeye çalıştıklarını dile getirerek, maliyeti azaltmak için de yeni diziler eklediklerini anlattı.
- "Geliştirdiğimiz aşıda soğuk zincire gerek kalmayacak"
mRNA teknolojilerinin belirli ısı koşullarında taşınması gerektiğine dikkati çeken Koçak, şunları kaydetti:
"Biz herhangi bir molekül yerine stabil ve etkin bir molekül oluşturma yönünde özellikle uğraştık. Geliştirdiğimiz aşıda soğuk zincire gerek kalmayacak. 6 ay kadar oda sıcaklığında dayanabilecek bir molekülle çalışmalarımızı yürütüyoruz. Üniversitemizdeki laboratuvarda Türkiye'nin ilk mRNA aşısını geliştirmiş olduk. Bundan 1,5 ay önce ilk mRNA aşısını geliştirdik ve hayvan deneylerine başladık. Hayvan denemelerinde de son aşamaya doğru gidiyoruz. Bundan başka farklı 3 tane daha prototip aşı dizayn ettik. Onların da sentezleri tamamlandı. En etkili olanla da 1,5-2 ay içinde insan denemelerine başlayacağız. Etkin ve ısıya dayanıklı bir aşı oluşturmayı amaçlıyoruz. Hedefimiz, yaz aylarında bu aşıyı insanlığın hizmetine sunmak."

- "Laboratuvarımızın ışıkları 6 aydır hemen hemen hiç sönmedi"
Koçak, salgın sürecinden dolayı faz çalışmalarının kısa tutulduğunu belirterek, tüm aşıların 3. fazda acil kullanım onayı aldığını bildirdi.

2-3 yıllık dönemde bu aşılarda tekrar doz ayarlamasına gidilebileceğini anlatan Koçak, "Şu anda ihtiyatlı olarak 2 doz olarak devam ediyor. Biz de benzer şekilde hayvanlar üzerinde ilk aşılamayı yaptık. İkinci dozu 2 hafta sonra uygulayacağız. Daha sonraki süreçte de aldığımız sonuçlara göre insan aşamasına geçeceğiz. Ekibimiz büyük bir özveriyle çalışıyor. Laboratuvarımızın ışıkları 6 aydır hemen hemen hiç sönmedi. Amacımız, olası bir salgın durumunda hemen devreye girip, dünya ölçeğinde mRNA teknolojisine dayalı aşı üretebilecek bir ekip oluşturmak." ifadelerini kullandı.

Türkçe karakter kullanılmayan ve büyük harflerle yazılmış yorumlar onaylanmamaktadır.